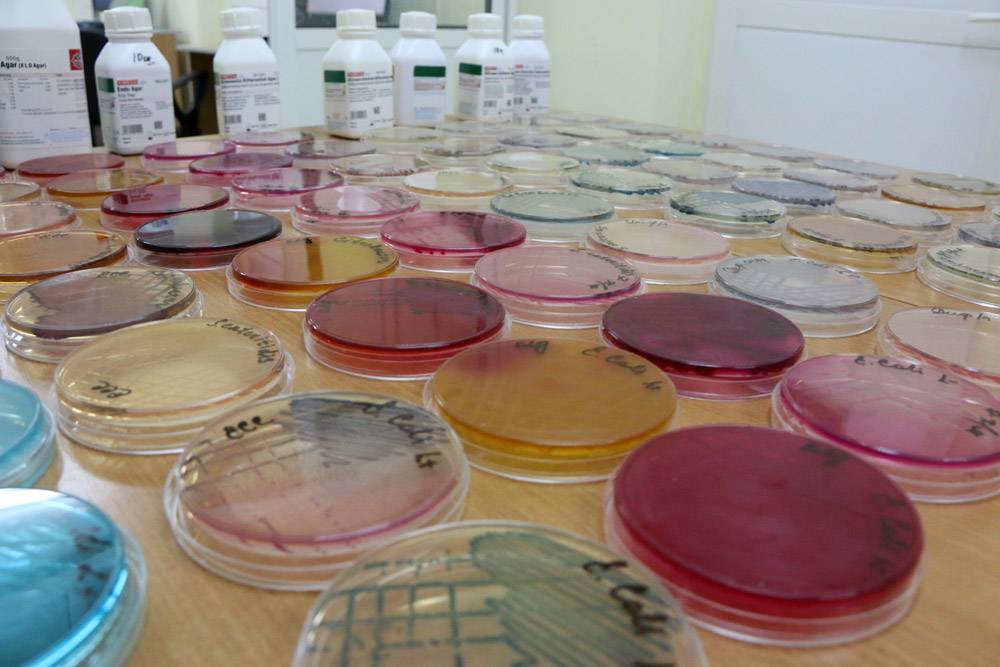

Основной целью мероприятий является создание муниципального центра тестирования комплекса ГТО в районе. Согласно недавним принятым изменениям в федеральное законодательство, отныне муниципальные районы вправе создавать подобные центры для выполнения нормативов комплекса.
В течение трех дней специалисты посетили спортивные объекты - места тестирования нормативов ГТО - спортивный зал «Илкит», детско-юношескую спортивную школу и спортивный зал общеобразовательной школы. После семинара по актуальным вопросам внедрения комплекса ГТО провели практическую часть - выполнение испытаний комплекса ГТО у учащихся 9-11 классов Оленекской средней школы и населения с. Оленек и Харыялах.
Напомним, что современный комплекс ГТО предусматривает подготовку к выполнению и непосредственное выполнение различными возрастными группами населения — от 6 до 70 лет и старше, установленных нормативов по 3 уровням трудности, соответствующим золотому, серебряному и бронзовому знакам отличия.
С января 2016 года стартует второй этап внедрения, в ходе которого планируется выполнение нормативов обучающимися всех образовательных организаций в центрах тестирования. Повсеместное внедрение комплекса ГТО и прием нормативов у всех групп населения планируется с 2017 года.

Комментарии
Авторизация на сайте через социальные сети